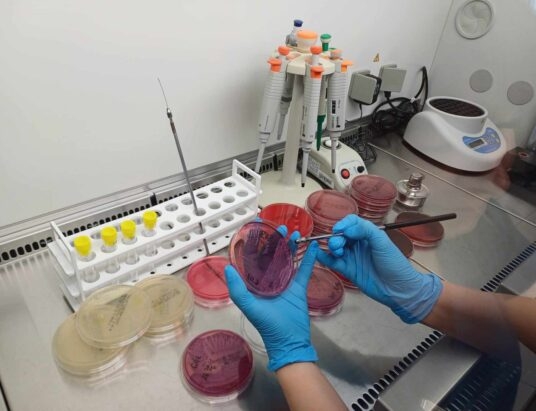
Laboratoria w Bielsku-Białej i Ustroniu wysoko ocenione w ogólnopolskich programach jakości. Co to oznacza dla pacjentów?

Wydarzenia

Będą ćwiczyć walkę w okopach
W weekend 21-22 lutego w bielskiej dzielnicy Mikuszowice będzie można spotkać umundurowane grupy osób z replikami broni. Odbędą się tu bowiem zajęcia terenowe z zakresu taktyki „walki w okopach”. Zajęcia, organizowane przez Jednostkę Strzelecką 3028 Czechowice-Dziedzice, będą się odbywać w godzinach 10.00-16.00 na terenie okopów 18 Batalionu Powietrzno-Desantowego. W trakcie zajęć nie zostaną użyte środki pozoracji. W rejonie bielskich Błoni będzie można spotkać umundurowane grupy osób z replikami broni. Uczestnicy zajęć zapewniają, że przeprowadzą ćwiczenia w sposób niezakłócający spokoju okolicznych mieszkańców.

Ostrzeżenie przed silnym mrozem. Od wieczora do rana
Od dzisiejszego wieczora do jutrzejszego poranka w powiatach bielskim, cieszyńskim i żywieckim prognozowany jest silny mróz. Instytut Meteorologii i Gospodarki Wodnej – Państwowy Instytut Badawczy Regionalne Biuro Prognoz Meteorologicznych w Krakowie wydało ostrzeżenie o silnym mrozie, który da się we znaki w trzech powiatach od piątku, 20 lutego od godz. 20.00 do soboty, 21 lutego do godz. 8.00. Na terenie powiatu bielskiego prognozuje się temperaturę minimalną w nocy od -16°C do -13°C i wiatr o średniej prędkości od 5 km/h do 15 km/h. Natomiast w powiatach cieszyńskim i żywieckim minimalna temperatura w nocy ma wynieść od -18°C do -15°C, a…

Nowy numer „Głosu Ziemi Cieszyńskiej” już w kioskach. Sprawdź, czym żyje region!
Podwyżki, wielkie plany inwestycyjne, powrót kultowego kina, sportowe emocje i wspomnienia historycznych chwil. Najnowsze wydanie…

Rusza budowa wiaduktu nad DK1. Zamkną lewe pasy
W poniedziałek, 23 lutego, rusza budowa wiaduktu nad DK1 w Czechowicach-Dziedzicach. W ostatnich miesiącach uzyskano…

Zmarł Jan Dzida – były dyrektor „Mechanika” i bielski radny
Minionej nocy w wieku 83 lat zmarł Jan Dzida – były bielski radny miejski, który…

Po zimie przegląd Galerii Beskidzkich Olimpijczyków. Czeka ją remont i aktualizacja
To szczególne miejsce na sportowej mapie Bielska-Białej powstało sześć lat temu. Ekspozycja umieszczona na Bulwarach…
- Niezgnieciona, nieopróżniona, nieodzyskana!
- Dobra wiadomość dla wędrujących po Beskidach: nowe punkty czerpania wody już dostępne dla turystów
- Nie masz umowy? Może Cię to drogo kosztować!
- Szukamy dziennikarza!
- Będą ćwiczyć walkę w okopach
- Ostrzeżenie przed silnym mrozem. Od wieczora do rana
- Nowy numer „Głosu Ziemi Cieszyńskiej” już w kioskach. Sprawdź, czym żyje region!
- Rusza budowa wiaduktu nad DK1. Zamkną lewe pasy
- Małe ogniwo, wielka odpowiedzialność
- Zmarł Jan Dzida – były dyrektor „Mechanika” i bielski radny
- Talent show inny niż wszystkie. Alien i Majtis o kulisach „Głosu Pokolenia” | WIDEO
- Po zimie przegląd Galerii Beskidzkich Olimpijczyków. Czeka ją remont i aktualizacja
- Czy przetrwa ciężką pracę na farmie? Bielszczanka w telewizyjnym reality show
- Trwają artystyczne ferie u Kossaków
- Lipnicki symbol polskości
- Dotacje i wsparcie dla lokalnych inicjatyw
- Blisko 400 tys. zł na sport i ponad 180 tys. zł na działania profilaktyczne
- Gmina Bestwina ostrzega przed naciągaczami
- Pracowita doba cieszyńskich strażaków. Powalone drzewa, drogowe kolizje, pożar w kominie i kot na drzewie
- Historia Małysza na wielkim ekranie. Ruszyły zdjęcia do filmu „Adam”
- Pieniądze na lądowisko przy szpitalu. Przyjmie nawet ciężkie śmigłowce wojskowe
- Śnieżyca postraszyła kierowców
- Zima nie daje za wygraną, więc policja przypomina o obowiązku usuwania z dachów śniegu i lodu
- Nowa Kronika: pytania o odśnieżanie, fortepian i szczury w Wapienicy
- Ile trzeba prosić o lustro? WIDEO
- Bohater igrzysk wrócił do domu. Królewskie powitanie w Bystrej
Sport

Prawie pół miliona złotych dla klubów sportowych z gminy Skoczów
Gmina Skoczów po raz kolejny wsparła lokalne organizacje realizujące zadania z zakresu kultury fizycznej. W ramach otwartego konkursu ofert dotacje na szkolenie sportowe otrzymało w tym roku 8 klubów, które zrealizują łącznie 11 projektów. Łączna kwota przyznanego wsparcia wynosi 465 tys. zł. Samorząd spod Kaplicówki od lat współpracuje z organizacjami pozarządowymi, wspierając inicjatywy sportowe i stwarzając w ten sposób mieszkańcom – zwłaszcza dzieciom i młodzieży – warunki do aktywnego spędzania czasu oraz rozwijania pasji i talentów. W tym roku najwyższą dotację otrzymał LKS Pogórze – 155 950 zł na szkolenia w sekcjach piłki nożnej, lekkoatletyki, narciarstwa klasycznego i tenisa stołowego.…

Zimny prysznic dla Rekordu. Legia wygrywa przy Startowej
Legia Warszawa wygrała w Bielsku-Białej z faworyzowanym Rekordem. I trzeba przyznać, że ekipa ze stolicy zapracowała sobie na to zwycięstwo. W pierwszej części to właśnie goście byli zespołem lepszym i skuteczniejszym. Pierwszą bramkę zdobyli już w 4 min. po strzale Oskara Szczepańskiego, a już dwie minuty później zmarnowali kolejną świetną sytuację. Zgodnie z zasadą, że niewykorzystane okazje się mszczą, gola zdobyli gospodarze: w swoim debiutanckim meczu przy Startowej sytuację sam na sam wykorzystał Miguel Kenji. Już po chwili Legioniści ponownie objęli jednak prowadzenie, po spóźnionym wyjściu przed pole karne Michała Kałuży. Tuż po rozpoczęciu drugiej połowy goście dołożyli trzecią bramkę,…

Mediolan-Cortina 2026: na trasie Dominik Bury i Aniela Sawicka
Dzisiaj (środa, 18 lutego) dwoje sportowców z naszego regionu zaprezentowało się na arenach trwających we…

Trzy medale z Bułgarii
Podczas Mistrzostw Europy Juniorów w Strzelectwie Sportowym w bułgarskim Burgas zawodniczki Bielsko-Bialskiego Klubu Sportowego Blaster…
- Prawie pół miliona złotych dla klubów sportowych z gminy Skoczów
- Miłosz Krzempek po ostatnim starcie na igrzyskach Mediolan-Cortina 2026
- Ćwierćfinał Przemka Koneckiego w czempionacie Europy
- Zimny prysznic dla Rekordu. Legia wygrywa przy Startowej
- Mediolan-Cortina 2026: na trasie Dominik Bury i Aniela Sawicka
- Miłosz Krzempek po kolejnym konkursie kombinacji norweskiej na igrzyskach
- Tomasiak i Wąsek wicemistrzami olimpijskimi. Niesamowite zwroty akcji w Predazzo
- Trzy medale z Bułgarii
- Anna Twardosz bez awansu do drugiej serii w olimpijskim konkursie na dużej skoczni
- Wygrana futsalistów Rekordu. Mecz miał jednego bohatera
- BKS wraca z Opola bez punktów
- Zastrzeżony numer legendy. Jego śmierć była szokiem
- Kacper Tomasiak znowu to zrobił! Drugi medal Bielszczanina
- Przyzwoity występ Polek w sztafecie w biegach narciarskich na włoskich igrzyskach
- Weronika Szczotka zdobyła medal mistrzostw Polski w skoku o tyczce
- Bramkarski talent przechodzi do Rakowa. To transfer definitywny
- Dominik Bury po biegu na 10 km podczas zimowych igrzysk olimpijskich
- Piłkarze i kibice… w teatrze. Takiej prezentacji jeszcze nie było
- Eliza Rucka-Michałek – najlepsza z Polek na 10 km | WIDEO
- Ligowa zaległość za dwa punkty. BKS – Stal 3:2
- Mediolan–Cortina 2026: Miłosz Krzempek po zawodach dwuboistów
- Twardosz, Tomasiak i Wąsek w nieudanym konkursie mikstów
- Kacper Tomasiak z medalem olimpijskim! WIDEO
- Uczennica z Cieszyna na podium Pucharu Polski w snowboardzie
- Puchar Polski nie dla BKS. Łodzianki z trofeum
Na sygnale

Działał metodą „na wypadek”. Pięć zarzutów dla oszusta
Od trzech seniorek odebrał łącznie ponad 100 tys. złotych. Dochodzenie prowadzone przeciwko 32–letniemu oszustowi zostało już zakończone. Do zatrzymania oszusta przez oświęcimskich policjantów, przy współpracy z policjantami z Komendy Wojewódzkiej Policji w Krakowie, doszło w połowie sierpnia 2025 roku – tuż po tym jak przejął on 40 tys. złotych oraz złotą biżuterię z rąk 81-letniej mieszkanki Oświęcimia. Przekazanie pieniędzy oraz wartościowych przedmiotów poprzedzone było wprowadzeniem kobiety w błąd podczas rozmowy telefonicznej z osobą podającą się za jej wnuka, który rzekomo miał spowodować poważny wypadek drogowy i potrzebował pieniędzy na kaucję. Policjanci, zatrzymując sprawcę, odzyskali pieniądze i złotą biżuterię, które zwrócono…

Trzech na jednego. Poszło o dziewczynę
Suscy kryminalni zatrzymali trzech mężczyzn, którzy we wtorkowy wieczór pobili 21-latka. Czym im zawinił? Ponoć spotkał się z dziewczyną jednego z agresorów. W środę (18 lutego) na Komisariat Policji w Makowie Podhalańskim zgłosił się 21-letni mieszkaniec powiatu suskiego, który poinformował, że poprzedniego wieczoru został pobity przez kilku mężczyzn, którzy ponadto zabrali jego telefon komórkowy. Do zdarzenia doszło w Zawoi: trójka podejrzanych zabrała pokrzywdzonego na przejażdżkę. – Gdy kierowca zatrzymał pojazd, w trakcie rozmowy mężczyźni mieli pretensje do pokrzywdzonego dotyczące kontaktu z dziewczyną jednego z podejrzanych. Słowa przerodziły się w rękoczyny, w trakcie których pokrzywdzonemu wypadł telefon komórkowy. Zanim podejrzani odjechali…

Przechodzień nie wahał się ani chwili. Może uratował czyjeś życie
Przechodzień nie pozostał obojętny na widom siedzącego na ławce zziębniętego mężczyzny i natychmiast wezwał na…

Uderzył w radiowóz, który zablokował mu drogę
Uciekał Volkswagenem przed policją, a następnie wypadł z jezdni, uderzył w ogrodzenie posesji, a następnie…
- Działał metodą „na wypadek”. Pięć zarzutów dla oszusta
- Trzech na jednego. Poszło o dziewczynę
- Przechodzień nie wahał się ani chwili. Może uratował czyjeś życie
- Uderzył w radiowóz, który zablokował mu drogę
- Potrącenie 23-latka na moście kolejowym w Skoczowie. Ruch wstrzymany na dwie godziny
- Zimno zabija. Reaguj, gdy widzisz kogoś w potrzebie
- Popisywał się na skrzyżowaniu. Na podstawie nagrania policjanci dotarli do 20-latka
- Brawurowa jazda w centrum miasta. BMW zatrzymano do kontroli FOTO
- Wpadł podczas nocnej jazdy na rowerze
- Z ostatniej chwili: Potrącenie na przejściu. Piesza doznała urazu kręgosłupa | ZDJĘCIA
- Seniorka i “inżynier z platformy wiertniczej”. To nie mogło się udać
- Potrącenie kobiety na przejściu! Poszkodowana z urazem głowy – foto
- Wandalowi nie uszło to płazem
Kultura i rozrywka

Dzień Języka Ojczystego w Wilamowicach
W sobotę, 21 lutego, w Muzeum Kultury Wilamowskiej w Wilamowicach odbędzie się 10. Dzień Języka Ojczystego (10. Mütérśpröhtag y Wymysöu). To wyjątkowe wydarzenie, które od dekady gromadzi mieszkańców regionu, badaczy oraz wszystkich zainteresowanych kulturą i językiem wilamowskim – żywym, używanym i przekazywanym kolejnym pokoleniom. Świętowanie rozpocznie się o 15.00 oprowadzaniem po wystawie stałej „Wilamowianie i ich sąsiedzi” w języku wilamowskim. Następnie zaprezentowane zostaną najnowsze publikacje w tym języku, a uczestnicy wysłuchają wykładów poświęconych różnorodności językowej – od Cypru po Meksyk i Vanuatu. Wydarzenie uświetni występ Zespołu Regionalnego „Wilamowice” oraz Pawła Szutowa. Zakończeniem dnia będzie premiera komedii „Cug uf Win” („Pociąg…
- Dzień Języka Ojczystego w Wilamowicach
- Gdy ciało, instrument i emocje stapiają się w jedno
- Ruszyła sprzedaż biletów na „Pasję Beskidzką” w Żywcu
- 544. rocznica nadania praw miejskich Strumieniowi – spotkanie z historią sprzed ponad stu lat
- Ostatni przystanek Projektu Zima w Wiśle. Na początek koncert Mandaryny
- Rozstrzygnięcie konkursu „Nie pisz do szuflady!” w Żywcu
- „Uwiecznione kredką: kunszt detalu” – nowa wystawa w „Domu Narodowym” w Cieszynie
- Grupy kolędnicze z Trójwsi Beskidzkiej nagrodzone podczas Góralskiego Karnawału w Bukowinie Tatrzańskiej
- 50 kadrów na 50 lat. Pokonkursowa wystawa w ROK-u
Na czasie

Jakub Sikora z ZSB Cieszyn wyróżniony w Turnieju Budowlanym „Złota Kielnia”
Jakub Sikora, uczeń Branżowej Szkoły I stopnia ZSB Cieszyn wywalczył III miejsce w Ogólnopolskim Turnieju Budowlanym „Złota Kielnia” w kategorii monter sieci i instalacji sanitarnych. Finał konkursu odbył się w Poznaniu podczas targów BUDMA 2026. Etap centralny 54. edycji konkursu miał miejsce w dniach 3–6 lutego roku na Międzynarodowych Targach Poznańskich. Targi BUDMA należą do czołówki branżowych wydarzeń na arenie międzynarodowej i co roku przyciągają przedsiębiorców z całego świata. Konkurs przebiegał dwuetapowo. Podczas trzech dni zmagań Jakub zaprezentował wysoki poziom wiedzy teoretycznej oraz umiejętności praktycznych, dzięki którym stanął na podium jako trzeci najlepszy instalator w kraju. – To ogromne osiągnięcie w…
- Jakub Sikora z ZSB Cieszyn wyróżniony w Turnieju Budowlanym „Złota Kielnia”
- Takich spotkań nigdy dość. O bezpieczeństwie podczas ferii
- Językowy sukces „Osucha”. Francuski otwiera uczniom drzwi do Europy
- Zamiast nudy – twórcza przygoda!
- Laptopy i tablety dla uczniów. Gmina Strumień stawia na kompetencje cyfrowe
- Od Ziarenka do Zenitu: spójna ścieżka edukacji od przedszkola do matury w Bielsku-Białej
- Czorne Łowiecki z Wisły podbiły Chiny
- Konkurs plastyczny na najpiękniejszą choinkę rozstrzygnięty!
- Sukces uczniów ZSP nr 2 w XXI Konkursie Gwar „Po cieszyńsku po obu stronach Olzy”
- Nowa Sala Bezpieczeństwa Ruchu Drogowego w SP nr 1 w Wiśle otwarta
Laboratoria w Bielsku-Białej i Ustroniu wysoko ocenione w ogólnopolskich programach jakości. Co to oznacza dla…
Badania laboratoryjne są jednym z kluczowych elementów współczesnej diagnostyki medycznej, stanowiąc podstawę decyzji dotyczących rozpoznania chorób, doboru terapii oraz monitorowania jej skuteczności. Z tego względu laboratoria medyczne podlegają regularnym, zewnętrznym ocenom jakości. Jedną z nich pomyślnie przeszły Laboratoria American Heart of Poland działające w Bielsku-Białej i Ustroniu, uzyskując pozytywną ocenę Centralnego Ośrodka Badań Jakości w Diagnostyce Laboratoryjnej. Zewnętrzna ocena jakości badań laboratoryjnych Centralny Ośrodek Badań Jakości w Diagnostyce Laboratoryjnej, działający przy ministrze zdrowia, realizuje ogólnopolskie programy oceny jakości badań laboratoryjnych, obejmujące różne dziedziny diagnostyki. Laboratoria American Heart of Poland w Ustroniu oraz Bielsku-Białej uzyskały pozytywną ocenę w programach realizowanych przez…
- Laboratoria w Bielsku-Białej i Ustroniu wysoko ocenione w ogólnopolskich programach jakości. Co to oznacza dla pacjentów?
- Profilaktyka raka piersi – powiat cieszyński liderem
- Od ciepłych dni do siarczystych mrozów. Jak zadbać o zdrowie zimą?
- Zamek Cieszyn zaprasza do udziału w XIX Konkursie na Cieszyńskie Ciasteczka
- Gdzie najlepiej ubezpieczyć samochód — przewodnik po rozsądnym wyborze polisy
- Ciche choroby XXI wieku – dlaczego nie zauważamy pierwszych sygnałów?
- Turystyczny Klub Kolarski PTTK Ondraszek zaprasza na wycieczkę rowerową do Chybia
- „Król cieszyńskich wypieków” bohaterem konkursu, pokazu i warsztatów
- Laboratorium Szpitala Pediatrycznego zachęca do badań tarczycy
- Spacer po srebrnej nitce – aktywny poranek dla seniorów w Jaworzu

Cieszyn: Z gruntu plecione. Przyjdź i zrób prezent dla bliskich
47 Drużyna Wędrownicza „Hestia” wraz z Serfentą oraz Fundacją Kupuj Odpowiedzialnie zapraszają na otwarte, proste, nieodpłatne i pełne dobrej energii warsztaty wyplatania, podczas których tworzone będą małe choineczki z wikliny i kolorowych sznurków. To idealna okazja, by przygotować wyjątkowy, własnoręczny prezent – bez pośpiechu, bez nadkonsumpcji, z poszanowaniem dla naszej ziemi. „Chcemy pokazać, że można inaczej: zamiast kupować – zrobić coś samemu i posłać dalej w świat dobrą, ręcznie wykonaną rzecz” – zachęcają organizatorzy. Wydarzenie odbywa się w ramach projektu Rural Voices 2030 i powstało dzięki współpracy Serfenty, Fundacji Kupuj Odpowiedzialnie oraz 47 Drużyny Wędrowniczej „Hestia”. Podczas spotkania uczestnicy projektu…
- Twoje zęby w doskonałym stanie
- Praktyczne rozwiązania do niewielkich wnętrz
- Jakie są filary nowoczesnego biznesu? Digitalizacja, outsourcing, procesy biznesowe
- Kleje i zaprawy klejowe – kiedy i do jakich materiałów można ich używać?
- Dlaczego kartony o uniwersalnych wymiarach (XS–M) dominują w e-commerce i logistyce?
- Gdzie wynająć domek? Zakopane, Kościelisko, Witów i okolice
- Grill gazowy Weber – ranking najpopularniejszych modeli na sezon 2026
- Złote sztabki 999,9 – co oznacza taka próba i gdzie je kupić
- Pierz sprawniej i skuteczniej – pralka Electrolux zadba o Twoje ubrania, by służyły Ci dłużej
- O czym pamiętać, dołączając do gastronomicznej sieci franczyzowej?
KontaktB24
Napisz do nasKontaktB24
Ustroń: Skarby na targu starociNa targach staroci można znaleźć różne cuda. Taki eksponat wpadł w oko naszej Czytelniczce w Ustroniu. Ponoć pochodzi ze Śląska Cieszyńskiego. To doskonały przykład recyklingu: …
Bielsko-Biała: “Miszcz” parkowania…Zdjęcie zrobił nasz czytelnik na parkingu Gemini. Mocno poirytowany zastanym obrazkiem. – Teraz, kiedy ruch w sklepach jest większy i ciężko znaleźć miejsce parkingowe, są …
Bielsko: „Pielęgnacja” brzóz. Łyso i smutno – ZDJĘCIADzisiaj od samego rana na bielskim osiedlu Polskich Skrzydeł prowadzono akcję przycinania drzew. Wszyscy mieszkańcy rozumieją, że gałęzie trzeba przyciąć, by na przykład podczas wichury …
Bielsko-Biała: Na Błoniach grasuje frytkojadWystarczyła chwila bezruchu i z talerza zniknęła frytka… Ten widoczny na fotografii skrzydlaty złodziejaszek zapożyczył chyba sposób na przekąskę od znanej w Morskim Oku orzechówki …
Abyśmy zdrowi byliNiedzielna kwarantanna?
- Cieszyńskie place zabaw zamknięte
Niestety, nie tylko pogoda nie sprzyja aktywności fizycznej na świeżym powietrzu. Z powodu epidemii koronawirusa zamknięte zostały place zabaw dla dzieci. Wszystko to w trosce …
Ustroń: Co dalej z tym skrzyżowaniem? (wideo)Od jednego z naszych Czytelników otrzymaliśmy film z kolizji, do której doszło dzisiaj w Ustroniu na skrzyżowaniu ulic Kozakowickiej, Dominikańskiej i Katowickiej. Na szczęście, jak …
To nie był wiatr!Wandale w Cieszynie nie odpuszczają. W ostatnim czasie wywrócili kontener na odpady. Rzecz ma miejsce na ulicy Kossak-Szatkowskiej w Cieszynie. O interwencje poprosił jeden z …
























